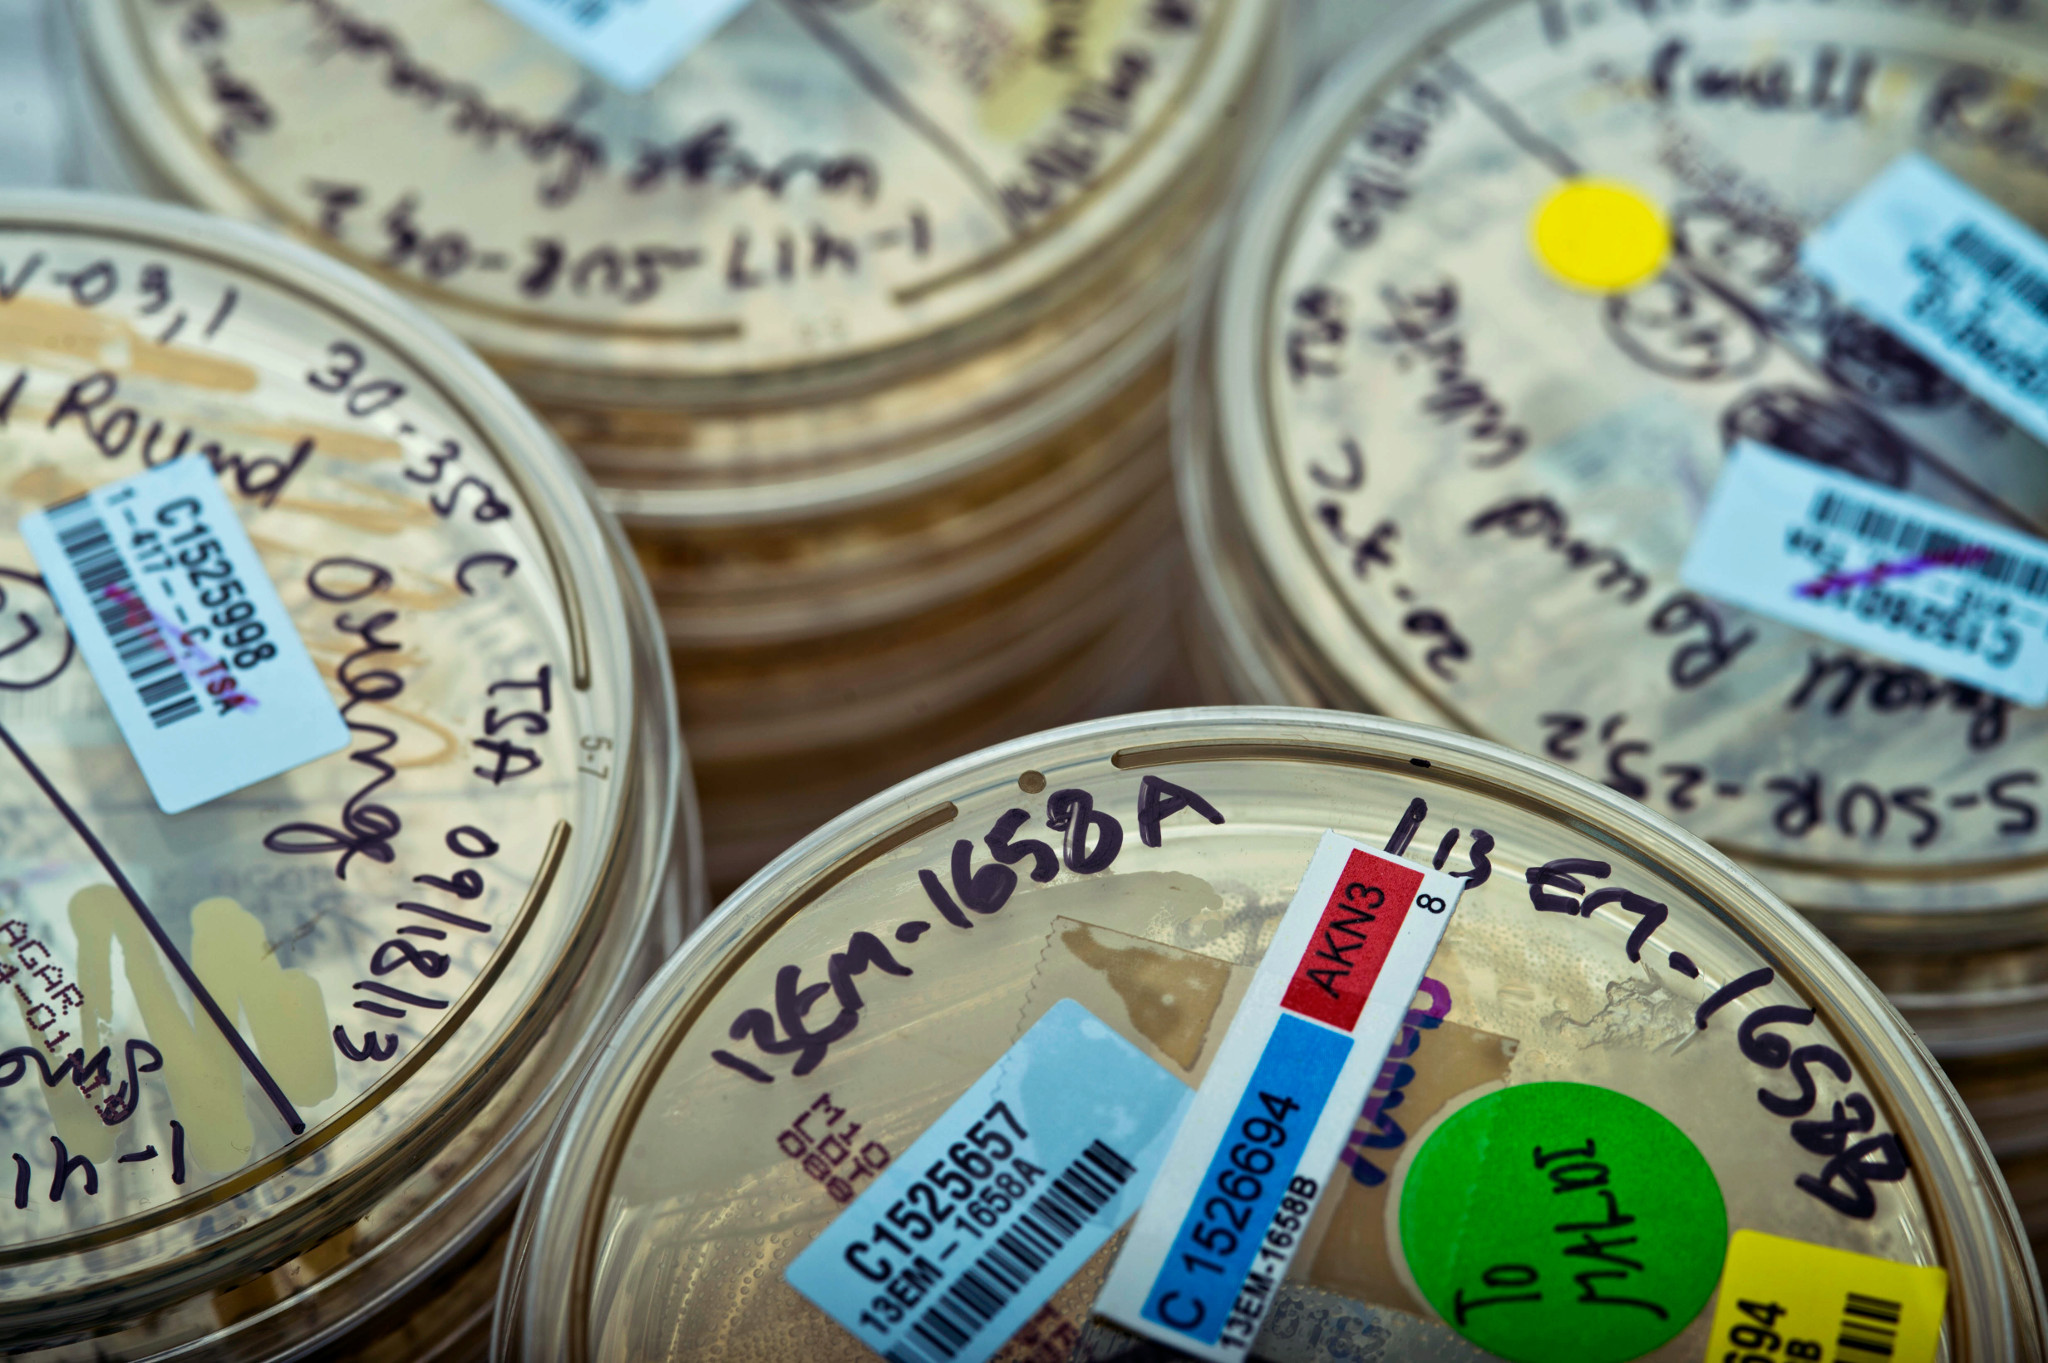
Stacks of labeled petri dishes, each marked with handwritten notes, barcodes, and colored stickers, arranged closely together in a laboratory setting.

Nutraceutical Product Testing for Microbial Identification
Dietary supplements, prebiotics and probiotics, functional foods and beverages, or other various health and wellness products often contain complex mixtures of natural ingredients that can be susceptible to a variety of microbial contaminants. In instances where contamination is detected in nutraceutical products, you need a quick and reliable method for ensuring the microbial quality of these products, that goes beyond traditional phenotypic methods in accuracy and reproducibility.
Our accurate Accugenix® identification services provide the necessary information to track down the source of contamination and assess and mitigate consumer risk. This is vital for implementing corrective measures and mitigating future occurrences. Understanding the specific microorganisms present can also aid in assessing the risk associated with the contaminant and in making informed decisions about product recalls or additional nutraceutical safety testing.
Nutraceuticals are diverse products and quality is imperative to their performance and safety. If making a probiotic, you will need to confirm that the efficacious microorganisms are present in your product. Just the same, when manufacturing nutraceuticals, products need to be free from unwanted and potentially harmful microbial contamination.
Our MALDI‑TOF microbial identifications provide a rapid, accurate, and cost‑effective solution for routine testing, supported by an industry‑leading spectra library optimized for bacteria, yeast, and fungi. When a species‑level identification cannot be confidently reached by MALDI‑TOF, our DNA sequencing methods (AccuGENX‑ID®) deliver definitive species resolution, enabling deeper insight for corrective and preventive actions in your environmental monitoring program.
Additionally, our single locus and multi-locus strain typing service is ideal for comparing bacteria of the same species to determine if your probiotic strains are indistinguishable or different from each other. The DNA sequences are compared to others in a database and the relationships are displayed in a phylogenetic tree, similar to a family tree. This strain-typing service provides clear insight into contamination sources by comparing DNA sequences of microbial contaminants. This resolution provides reliable results, detailed strain comparisons, evolutionary insights, and highthroughput processing for fast, scalable workflows and easy-to-interpret reports.
View Microbial Identification Services
Live Webinar: Turn Crisis into Control with Strain Typing
Discover how strain typing technologies could stop recurring contamination and support your contamination control strategy. Live on February 25, 2026.
Register Now
Master Your Microbial Identification Data with Ease
Discover the power of seamless data management with the Accugenix® Customer Web Portal. This secure, intuitive platform revolutionizes the way you submit and analyze microbial samples for identification. With a comprehensive tracking and trending system, the portal adeptly handles all environmental isolates identified using Accugenix services.
Key Features:
- Customizable data entry fields and reports tailored to your specific needs
- Compliance with 21 CFR Part 11 requirements ensuring data integrity and security
- Advanced functionalities to sort and filter specific organisms enabling precise data analysis
- Detailed insights into the frequency of occurrence, Gram reaction, and other critical data points
For added convenience, access the portal on the move with our mobile app. Simply search for “Accugenix” in the App Store or Google Play and stay connected with your ID data anytime, anywhere.
Toxicology Studies
Meet regulatory requirements for all your toxicology testing needs. Our exceptional team of scientists regularly design and perform nutraceutical safety testing programs ranging from acute through chronic toxicity and carcinogenicity studies. A broad range of in vitro and in vivo options are available as well as numerous routes of administration.
-
Toxicology Services for Nutraceutical Testing
- Non-GLP Acute Toxicology Studies
- General Toxicology
- Developmental and Reproductive Toxicology
- Ocular Toxicology
- Infusion Toxicology
- Inhalation Toxicology
- Musculoskeletal Toxicology
- Neurotoxicology
- Abuse and Dependence Liability Testing
- Genetic Toxicology
- In Vitro Toxicology
- Ocular Irritation Models
- Ototoxicity Testing
- Infectious Disease Models
- Phototoxicity Testing
- Skin Irritation, Corrosion and Sensitization
- REACH Services
- Field Trials
- Human Exposure Studies
- Radiation Biology
- Seizure Liability Testing
- Genomic Services
-
Formulation Development
Our experts can assist with product chemistry testing, solubility studies, stability testing, analytical method development and validation, and more. Formulation development services range from pre-formulation investigations to analytical method development and validation. We prepare formulations based on our extensive knowledge of vehicle suitability in animal models.
- pH solubility profiling assessments
- Dose suitability
- Compatibility
- Bioavailability enhancement
- Routes of administration:
- Oral
- Dietary
- Parenteral
- Inhalation
- Topical
-
Analytical Chemistry
- High performance liquid chromatography (HPLC)
- Ultra-high performance liquid chromatography (UPLC)
- Gas chromatography (GC)
- Liquid chromatography/mass spectrometry (LC-MS and LC-MS/MS)
- Atomic absorption spectroscopy (AAS)
- Inductively coupled plasma (ICP-OES, ICP-MS)
- UV/Vis spectroscopy
- Fourier transform infrared (FTIR) spectroscopy
- Capillary electrophoresis (CE)
- Karl Fischer titration
- Nuclear magnetic resonance
- Differential scanning calorimetry
- Thermogravimetric analysis (TGA)
- Laser diffraction
- Dynamic light scattering (DLS)
- Gravimetric vapor sorption
- Particle Sizing
Regulatory Complexity
Navigating varying regulations across different markets can be cumbersome for businesses. It's essential for companies in the nutraceutical industry to comply with the relevant regulations, including labeling requirements and safety standards to ensure consumer safety and product quality.
Global regulations of nutraceutical and functional food
| Country/Territory | Name of Regulation |
|---|---|
| USA | Dietary Supplement Health and Education Act, 1994 |
| China | State Food and Drug Administration of China (SFDA), 2003 |
| Japan | FOSHU (Food for specified Health Uses), 1991 |
| France | French Act on regional Health Governance |
| Korea | The Health/Functional Food Act, 2002 |
| Europe | Functional Food Science in Europe (FUFOSE), 1996 regulations |
| India | The Food Safety and Standards Act (FSSA), 2006 |
| Canada | Natural Health Products Directorate (NHPD), 2003 |
| Australia | Australian guidelines for complementary Medicines |
| Nepal | Dietary Supplement guidelines, 2016 |
| Taiwan | Health Food Control Act (HFCA), 1999 |
| Philippines | Food Fortification Act, 2000 |
| Malaysia | The Food Act, 1983 |
Source: Herbs, Spices and Their Roles in Nutraceuticals and Functional Foods book, Chapter 1; 2023
Ensure Product Quality
Frequently Asked Questions (FAQs) About Nutraceutical Testing
-
What are nutraceuticals?
Nutraceuticals tailored to individual health needs and genetic profiles are gaining popularity. As consumers have become more aware of their health and wellness, their interest in preventive healthcare grows as well. Nutraceuticals encompass a wide range of products, including dietary supplements, functional foods and beverages, as well as various health and wellness products.